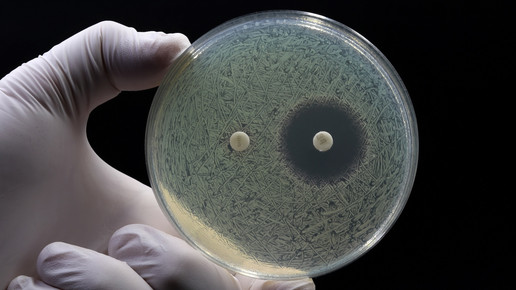
Antibiotika: Mehr Resistenzen bei geringerer Produktion

Antibiotika: Mehr Resistenzen bei geringerer Produktion
Jährlich sterben in der EU Zehntausende Menschen an Infektionen durch antibiotikaresistente Erreger, während der Nachschub mit neuen Antibiotika stockt. Expert:innen fordern intensivere Maßnahmen gegen Antibiotikaresistenzen, da vielversprechende Forschungsansätze oft nicht umgesetzt werden. Rund 50 Prozent der Pharmaunternehmen stellen die Produktion von Antibiotika aus wirtschaftlichen Gründen ein.
Der Kampf gegen Antibiotikaresistenzen muss aus Sicht von Experten deutlich intensiviert werden. Es gebe viele neue und vielversprechende Forschungsansätze, sagte Professor Dr. Mark Brönstrup vom Deutschen Zentrum für Infektionsforschung (DZIF). Viele dieser Ansätze würden jedoch nicht umgesetzt. Das Problem sei, dass Pharmaunternehmen zunehmend die Produktion von Antibiotika aufgäben, weil sich diese wirtschaftlich nicht rentiere. Das bestätigte zuletzt auch eine Mitgliederbefragung von Pro Generika.
Laut Angaben der EU-Gesundheitsbehörde ECDC sterben jährlich allein in der EU etwa 35.000 Menschen an Infektionen durch antibiotikaresistente Erreger. „Wir sind gerade dabei, die Errungenschaften der modernen Medizin wieder zu verlieren und in die Zeit vor der Entdeckung von Penicillin zurückzufallen“, warnte PEG-Vize-Präsident Professor Dr. Mathias Pletz in Weimar. Die Wirksamkeit von Antibiotika sei zunehmend gefährdet, was einen zurückhaltenden Einsatz und fortlaufend neue, resistenzbrechende Mittel erfordere.
Resistenzbildungen sind ein Problem
Die Bundesregierung müsse dringend Anreize schaffen, damit Pharmaunternehmen wieder in die Produktion von Antibiotika investieren, hieß es weiter. Aktuell hätten Unternehmen bei der Entwicklung neuer Medikamente nur eine begrenzte Zeit das Recht zur Exklusivvermarktung, erklärte Harald Zimmer, Sprecher des Deutschen Netzwerks gegen Antimikrobielle Resistenzen und Referent des Verbands der forschenden Pharmaunternehmen (vfa).
Antibiotika seien wegen der Resistenzbildung zu früh unwirksam, sodass die Unternehmen die Entwicklungskosten meist nicht wieder hereinbekämen. Viele Unternehmen, die sich auf die Entwicklung von Antibiotika spezialisiert hatten, seien bereits pleitegegangen. Daher müsse ein EU-Vorschlag umgesetzt werden, der den Firmen erlaube, andere Medikamente länger exklusiv zu vermarkten, um damit die Antibiotika-Entwicklung zu finanzieren.
Ersatzmarkt gefordert
Derzeit seien 80 Prozent der Forschungsprojekte zu neuen Antibiotika in den Händen kleiner Start-Ups, so Zimmer. Diese Firmen stünden unter massivem Finanzierungsdruck und hätten oft keine anderen Medikamente, die sie exklusiv vermarkten könnten. Daher müsse ein Ersatzmarkt geschaffen werden, auf dem diese Unternehmen das Recht auf längere Exklusivvermarktung an andere Pharmaunternehmen verkaufen könnten.
Die Tatsache, dass seit 2017 nur zwölf neue Antibiotika zugelassen wurden, ist alarmierend. Zehn davon gehören zu Klassen, gegen die sich bereits Resistenzmechanismen gebildet haben. „Der Patient hat eigentlich nichts davon“, sagte Brönstrup. Laut dem Robert Koch-Institut töten Antibiotika nicht alle Bakterien; die resistenten überleben und vermehren sich weiter. Die Entstehung von Resistenzen könne nicht verhindert, sondern nur verlangsamt werden.

APOTHEKE ADHOC Debatte